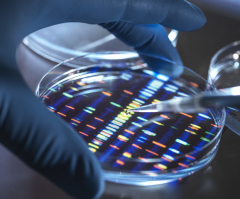
Is engineering a ‘super’ human being a good idea?

Richard D. Land
Christian Post Executive Editor
Dr. Richard Land, BA (magna cum laude), Princeton; D.Phil. Oxford; and Th.M., New Orleans Baptist Theological Seminary, was president of the Southern Baptists’ Ethics & Religious Liberty Commission (1988-2013) and has served since 2013 as president of Southern Evangelical Seminary in Charlotte, NC. Dr. Land has been teaching, writing, and speaking on moral and ethical issues for the last half century in addition to pastoring several churches.
Latest

The Russo–Ukrainian war continues: How to end it justly
To date, the Russo-Ukrainian war has already become the bloodiest war on the European continent since the end of World War II.

The Rob Reiner tragedy: How should Christians respond?
Like tens of millions of Americans, I was shocked by the heartbreaking and tragic deaths of prizewinning film director Rob Reiner and his gifted photographer wife, Michele.

María Corina Machado is truly a heroine for our time
The flame of freedom still burns brightly and has lost none of its power to inspire human hearts and spirits.

The Johnson Amendment: Rest in peace?
It is likely that this case will go all the way to the Supreme Court, and it is very likely that this present Supreme Court will jettison the Johnson Amendment before our next presidential election,

America's stunning lack of academic freedom: As seen in this viral post
Fulnecky complained through her Turning Point USA chapter, which then posted the story on X, which generated 35 million views in 7 days.

This Thanksgiving season makes me think of the American Revolution
The Founding Fathers were the first human beings to assert that people were citizens, and had the right to elect their government and hold it accountable to the people.

I'm grateful to President Trump putting pressure on Nigeria
How long will our nation continue to largely ignore the terrible persecution being endured by Nigerians, the majority of whom are Christians?
Is engineering a ‘super’ human being a good idea?
When we start trying to engineer human beings, we are in way over our heads ethically and morally.

Why Zohran Mamdani won and New York will pay a terrible price
How did New York City, arguably the world capital of capitalism, elect a Democratic Socialist (on a good day) and a Communist (on a bad day) mayor?

The most predictable scandal in recent sports history
Along with many others, I have been waiting with bated breath for several years now for such a scandal to break.



















